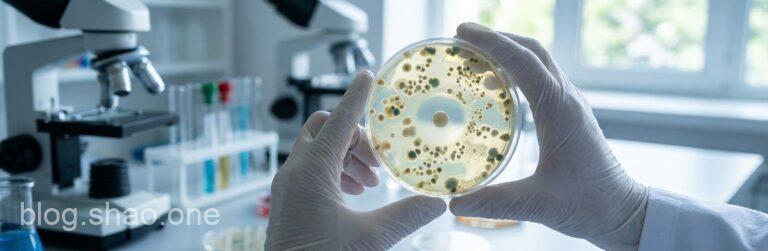
1766216773641

深入地底 1 萬公尺!中國「深地一號」在死亡之海挑戰地心極限,是科研還是找油?

【科技快報】星際嬌客 3I/ATLAS 降臨!倒數兩小時掠過地球,這場「宇宙級大秀」你準備好了嗎?

虛空暗影壟罩艾澤拉斯!《魔獸世界:午夜》前夕改版 1 月 20 日震撼登場:UI 翻新與職業大改全攻略

【硬體警報】想打《特戰英豪》卻被拒之門外?Riot 揭露主機板「後門」漏洞,MSI 與 Asus 急推更新!

畫圈圈就能修圖?Google Gemini 迎來「Nano Banana」黑科技,SynthID 讓 AI 影片無所遁形!

【科技新知】起司控的勝利!25年研究證實:每天吃這份量,大腦老化「卡慢一點」

Naughty Dog 爆肝文化回歸?《Intergalactic》新作 Demo 趕工,Sony 旗下「神作製造機」再陷加班爭議
腸道健康守護神!「超級抗生素」EVG7 橫空出世:精準打擊艱難梭菌,守護你的微生態平衡

《Horses》銷量破萬仍「命懸一線」?獨立遊戲的藝術冒險與平台的審查之牆

2025 登山車界「黑科技」大噴發?從 Pinkbike 年度清單看單車裝備新趨勢!
